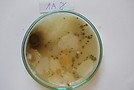

Studenckie koła naukowe
Studenckie Koła Naukowe w Zakładzie Towaroznawstwa
Studenckie Koło Naukowe „Towaroznawców” powołane zostało z inicjatywy grupy studentów kierunku Towaroznawstwo w Państwowej Wyższej Szkole Zawodowej im. S. Pigonia w Krośnie. Celem Koła jest rozwijanie i pogłębianie wiedzy związanej z szeroko pojętą dyscypliną towaroznawstwa. Studenckie Koło Naukowe zostało założone przez studentów, którzy w praktyczny sposób chcą wykorzystać wiedzę zdobytą podczas studiów oraz rozwijać swoje zainteresowania związane z poszerzaniem wiedzy i pracą naukową w zakresie technologii żywności, biotechnologii, towaroznawstwa przemysłowego. Badania prowadzone przez SKN Towaroznawców obejmują analizy chemiczne, instrumentalne oraz ocenę sensoryczną żywności. Studenci doskonalą umiejętności pracy w laboratorium. Cele Koła realizowane są poprzez doskonalenie wiedzy, opracowywanie projektów naukowych, uczestnictwo w konferencjach i seminariach naukowych oraz przygotowywanie artykułów naukowych na podstawie przeprowadzonych badań.
Opiekunowie naukowi Koła: dr inż .Małgorzata Górka, dr inż.Damian Dubis
Członkowie Koła Naukowego Towaroznawców uczestnikami V konferencji naukowej pt. Rośliny zielarskie, kosmetyki naturalne i ....
W dniach 10-11 maja 2018 roku w Państwowej Wyższej Szkole Zawodowej im. Stanisława Pigonia w Krośnie odbyła się V konferencja naukowa pt. Rośliny zielarskie, kosmetyki naturalne i żywność funkcjonalna. Nowe nadzieje fitoterapii.
W konferencji uczestniczyli Członkowie Koła Naukowego Towaroznawców prezentując w formie posterów wyniki badań:
Kamila Kras, Elżbieta Zawidlak, Aleksandra Hart, Michał Fiejdasz
Jakość kaw mielonych i ziarnistych na podstawie oceny potencjału antyoksydacyjnego
Quality of ground coffee and coffee beans on the basis of evaluation of antioxidant potential
Urszula Folcik, Monika Gumienna, Oliwia Dziedziak, Karolina Majdosz
Jakość win czerwonych na podstawie oceny zawartości polifenoli
Quality of red winesbased on the evaluation of polyphenolcontent
Aktywność członków SKN Towaroznawców w roku akademickim 2017/2018
- Udział w „Nocy Biologów” - organizowanej przez PWSZ w Krośnie
- Promocja kierunku Towaroznawstwo i koła naukowego podczas targów "Ekogala 2017" Międzynarodowe Targi Produktów i Żywności Wysokiej Jakości w Jasionce k.Rzeszowa
- Udział w V Targach Pracy PWSZ w Krośnie w ramach Akademickich Dni Nauki
- Udział w V konferencji pt. Rośliny zielarskie, kosmetyki naturalne i żywność funkcjonalna. Nowe nadzieje fitoterapii.
- Przygotowanie artykułu na stronę www Zakładu Towaroznawstwa pt. „Kariera zawodowa absolwenta kierunku Towaroznawstwo”
Studenckie Koło Naukowe Towaroznawców rozpoczyna pracę w roku akademickim 2017/2018
W dniu 30 listopada 2017 roku odbyło się spotkanie Studenckiego Koła Naukowego Towaroznawców. Spotkanie było okazją do wyboru nowych struktur władz oraz wyznaczeniem sobie nowych kierunków działań i zadań do realizacji. Nowym przewodniczącym koła została Kamila Kraś a sekretarzem Monika Gumienna z I roku kierunku Towaroznawstwo.
Wykaz zadań przewidzianych do realizacji przez członków
Studenckiego Koła Naukowego Towaroznawców
w roku akademickim 2017/2018
- propagowanie misji i roli towaroznawstwa jako nauki o jakości podczas wizyt w szkołach, targów, dni otwartych, nocy nauki, festiwalu nauki,
- wykonanie badań i analiz z zakresu towaroznawstwa. Opracowywanie rozwiązań rozwojowych i projakościowych,
- przygotowanie publikacji naukowych,
- udział w konferencjach i seminariach wyjazdowych i organizowanych przez Uczelnię,
- udział w szkoleniach i warsztatach,
- ogłoszenie konkurs na logo Studenckiego Koła Naukowego Towaroznawców,
- opracowanie materiałów informacyjnych i promocyjnych na stronę www oraz front page facebook Zakładu Towaroznawstwa,
- nawiązanie współpracy z innymi Kołami Naukowymi Towaroznawców.
Aktywność członków SKN Towaroznawców w roku akademickim 2016/2017
- udział w warsztatach dla szkół ponadgimnazjalnych nt. „Jak samodzielnie przygotować mieszanki przypraw”
- udział w warsztatach dla szkół ponadgimnazjalnych nt. „Jak przygotować cukierki żelki”
- udział w warsztatach dla szkół ponadgimnazjalnych nt.” Przygotowanie naturalnych kosmetyków: mydeł, peelingów, musujących kul do kapieli”.
- udział w IV Targach Edukacji i Zatrudnienia: prezentacja posterów pt.
- „Preferencje konsumentów w zakresie spożycia ziołomiodów”,
- „Preferencje konsumentów w zakresie spożycia miodów”
- przeprowadzenie oceny konsumenckiej wybranych miodów i ziołomiodów.
- pomoc przy organizacji Konferencji pt. „Borelioza – problemy diagnostyczne i terapeutyczne”
- pomoc przy organizacji Konferencji pt „Rośliny zielarskie, kosmetyki naturalne i żywność funkcjonalna. Medycyna naturalna w onkologii”
Publikacje członków SKN Towaroznawców w roku akademickim 2015/2016
1. Agnieszka Szydło, Natalia Grzesik. 2016. "Produkty tradycyjne i regionalne w województwie podkarpackim" – poster - III Międzynarodowa Konferencja Pasterska „Krajobraz kulturowy Karpat – wspólne dziedzictwo człowieka i przyrody". Zakopane
2. Agnieszka Szydło, Natalia Grzesik. 2016. "Zasoby zwierzyny łownej w województwie podkarpackim" – poster - III Międzynarodowa Konferencja Pasterska „Krajobraz kulturowy Karpat – wspólne dziedzictwo człowieka i przyrody". Zakopane
3. Kinga Śnieżek, Joanna Słota. 2016. Preferencje konsumentów w zakresie zakupu i spożywania produktów mlecznych. XLV Seminarium Studenckich Kół Naukowych organizowane przez Uniwersytet Warmińsko-Mazurski w Olsztynie w dniach 25 kwietnia 2016 roku.
4. Kinga Śnieżek, Joanna Słota. 2016. Preferencje konsumentów w zakresie zakupu i spożywania miodów . XLV Seminarium Studenckich Kół Naukowych organizowane przez Uniwersytet Warmińsko-Mazurski w Olsztynie w dniach 25 kwietnia 2016 roku.
5. Dominika Krochmal, „Czynniki warunkujące zakup czekolady przez konsumentów powiatu krośnieńskiego” V Konferencja Naukowa „Studenckie Dni Jakości – Rola towaroznawstwa w kształtowaniu współczesnego rynku”, 25-26 lutego 2016 roku.
Udział członków SKN Towaroznawców w konferencjach naukowych
Członkowie SKN Towaroznawców brali udział w następujących konferencjach naukowych:
1. III Międzynarodowa Konferencja Pasterska „Krajobraz kulturowy Karpat – wspólne dziedzictwo człowieka i przyrody". 7-8 marca 2016 w Zakopanem
2. XLV Seminarium Studenckich Kół Naukowych organizowane przez Uniwersytet Warmińsko-Mazurski w Olsztynie w dniach 25 kwietnia 2016 roku.
3. III Międzynarodowa konferencja "Rośliny zielarskie, kosmetyki naturalne i żywność funkcjonalna. Bezpieczeństwo żywności i pasz", 12 – 13 maja 2016 roku organizowana przez Państwową Wyższą Szkołę Zawodową im. S. Pigonia w Krośnie.
III Ogólnopolska Konferencja Studenckich Kół Naukowych w Krośnie
W dniu 5 maja 2015 roku w Państwowej Wyższej Szkole Zawodowej w Krośnie odbyła się III Ogólnopolska Konferencja Studenckich Kół Naukowych - Badania i innowacje z perspektywy młodego naukowca.
Celem konferencji było stworzenie płaszczyzny do rozwijania naukowych zainteresowań studentów, wymiana doświadczeń a także tworzenie inicjatyw w poszukiwaniu nowych rozwiązań dla doskonalenia i rozwoju gospodarki.
Konferencja odbyła się w następujących panelach tematycznych:
I - Wyzwania zdrowia, aktywności fizycznej i żywienia człowieka w XXI wieku
II - Dylematy, wyzwania i perspektywy współczesnej działalności gospodarczej
III - Innowacje technologiczne w życiu codziennym
IV - Zmiany w języku i kulturze współczesnej
V - Turystyczna aktywność studentów i studenckich kół naukowych
VI - Edukacja wobec wyzwań współczesności
W konferencji czynny udział wzięli studenci kierunku Towaroznawstwo. Studentki SKN Towaroznawców Patrycja Kuzian i Joanna Wójcik w ramach I panelu wygłosiły referat pt. Wykorzystanie nanorobotów w medycynie. Za wystąpienie i innowacyjność badań zostały wyróżnione III miejscem w swoim panelu. Referat został przygotowany pod opieką opiekuna koła naukowego dr inż. Janusza Kilara.
W sprawy organizacyjne zaangażowane były studentki II roku Towaroznawstwa Kinga Śnieżek oraz Joanna Słota.
Dziękujemy studentom za zaangażowanie, gratulujemy wyróżnień i życzymy dalszych sukcesów naukowych.
XLIV Seminarium Studenckich Kół Naukowych w Olsztynie
W dniach 27-28 kwietnia w Olsztynie odbyło się XLIV Seminarium Studenckich Kół Naukowych. W seminarium wzięły udział studentki PWSZ Joanna Słota i Kinga Śnieżek.
Zaprezentowały publikację pt. "Produkty tradycyjne i regionalne z Podkarpacia" oraz e-poster pt. "Analiza preferencji konsumentów dotycząca spożycia napojów mlecznych fermentowanych" przygotowany na podstawie własnych badań ankietowych. Wieczorem odbyła się biesiada dla wszystkich uczestników konferencji w bardzo malowniczej okolicy Olszyna. W drugim dniu uczestnicy zwiedzali miasto i zabytkowe budowle w okolicy.
Studentki Studenckiego Koła Naukowego Towaroznawców na IV Konferencji Studenckich Dni Jakości
Konferencja naukowa Studenckie Dni Jakości, organizowana przez Naukowe Koło Towaroznawstwa „CARGO” działające przy Akademii Morskiej w Gdyni, odbyła się w dniach 26-27 lutego 2015 roku. Jej hasło przewodnie brzmiało: „Towaroznawstwo w zrównoważonym rozwoju”. W ramach bloku tematycznego „Rola współczesnego towaroznawstwa w kreowaniu innowacyjnych technologii” studentki towaroznawstwa PWSZ w Krośnie – Patrycja Kuzian i Joanna Wójcik, przedstawiły prezentacje zatytułowane: „Nanotechnologia w budownictwie” oraz „Nanotechnologia w medycynie, farmacji i kosmetyce”.
Celem pierwszego wystąpienia było ukazanie wpływu nanotechnologicznych rozwiązań na rozwój budownictwa. Został zaprezentowany m.in. wpływ grafenu na poprawę wytrzymałości materiałów kompozytowych, korzyści z wykorzystania nanorurek jako elementów zbrojenia betonu, a także samooczyszczanie i samonaprawialność betonu.
Drugi wystąpienie obejmowało ukazanie zastosowania nanocząstek srebra, tlenku cynku(II), złota, platyny czy miedzi w medycynie oraz przemyśle farmaceutycznym i kosmetycznym. Zostały również zaprezentowane nowoczesne metody wykorzystujące nanotechnologię w diagnostyce i leczeniu nowotworów.
Dzięki wspaniałej organizacji w ramach konferencji uczestnicy mieli okazję zwiedzić statek „Dar Pomorza” oraz planetarium, a także uczestniczyć w imprezie integracyjnej w Klubie Studenckim „Bukszpryt”.
Poza priorytetowymi walorami edukacyjnymi wyjazd miał również formę rekreacyjną. Krośnieńskie studentki na czele ze wspaniałą opiekun-przewodnik - dr Anną Pietrasz, miały okazję zobaczyć molo w Orłowie, Stare Miasto w Gdańsku czy molo w Sopocie.
Publikacje członków SKN Towaroznawców na III Международной научной студенческой конференции “Рыночная экономика: сегодня и завтр
- Matysik-Gliwa J., Ginalska E., mgr inż. Kilar M. 2014. Systems assuring high quality of food products. Materiały III Международной научной студенческой конференции «Рыночная экономика: сегодня и завтра», в Белорусском Государственном Aграрном Tехническом Yниверситете 27-28 февраля 2014 года.
- Batko S., Olejarz K., dr inż. Kusz D. 2014. Traditional and regional products in the opinion of consumers in Poland. Materiały III Международной научной студенческой конференции «Рыночная экономика: сегодня и завтра», в Белорусском Государственном Aграрном Tехническом Yниверситете 27-28 февраля 2014 года.
- Okarmus A., Wydro M., dr inż. Zając S. 2014. HACCP as a quality assurance system in the agri-food sector. Materiały III Международной научной студенческой конференции «Рыночная экономика: сегодня и завтра», в Белорусском Государственном Aграрном Tехническом Yниверситете 27-28 февраля 2014 года.
- Czarnik A., Ogryzek J., prof. dr hab. Eng. Ruda M. 2014. Student as a juice consumer. Materiały III Международной научной студенческой конференции «Рыночная экономика: сегодня и завтра», в Белорусском Государственном Aграрном Tехническом Yниверситете 27-28 февраля 2014 года.
Studentki SKN Towaroznawców na konferecji naukowej w Tarnobrzegu
W dniu 10.04. 2014 Studentki Koła Naukowego Towaroznawców pani Ewelina Ginalska oraz pani Jowita Matysik-Gliwa wzięły udział w V Ogólnopolskiej Sesji Kół Naukowych pt. „Wyzwania XXI wieku – Człowiek, kultura, nauka, postęp” w Państwowej Wyższej Szkole Zawodowej im. prof. S. Tarnowskiego w Tarnobrzegu. W trakcie konferencji został zaprezentowany referat na temat " Preferencje konsumentów dotyczące spożycia miodów".
Studentki Koła Naukowego Towaroznawców na konferencji naukowej
Studentki Koła Naukowego Towaroznawców w dniu 18 kwietnia zaprezentowały na I Międzynarodowej Konferencji “Ziołolecznictwo, biokosmetyki i żywność funkcjonalna” postery: Marlena Wójtowicz “Wpływ lipofilowości surowców kosmetycznych na przenikanie przez skórę”, Agnieszka Szałankiewicz “Właściwości ekstraktów roslinnych bogatych w bioflawonoidy”, Jolanta Gazda “Ekstarkcja flawonoidów z wybranych surowców roślinnych (zielona herbata)”
Doświadczenia w laboratorium mikrobiologii - ocena mikrobiologiczna pomieszczeń
Doświadczenia w laboratorium mikrobiologii - ocena mikrobiologiczna pomieszczeń